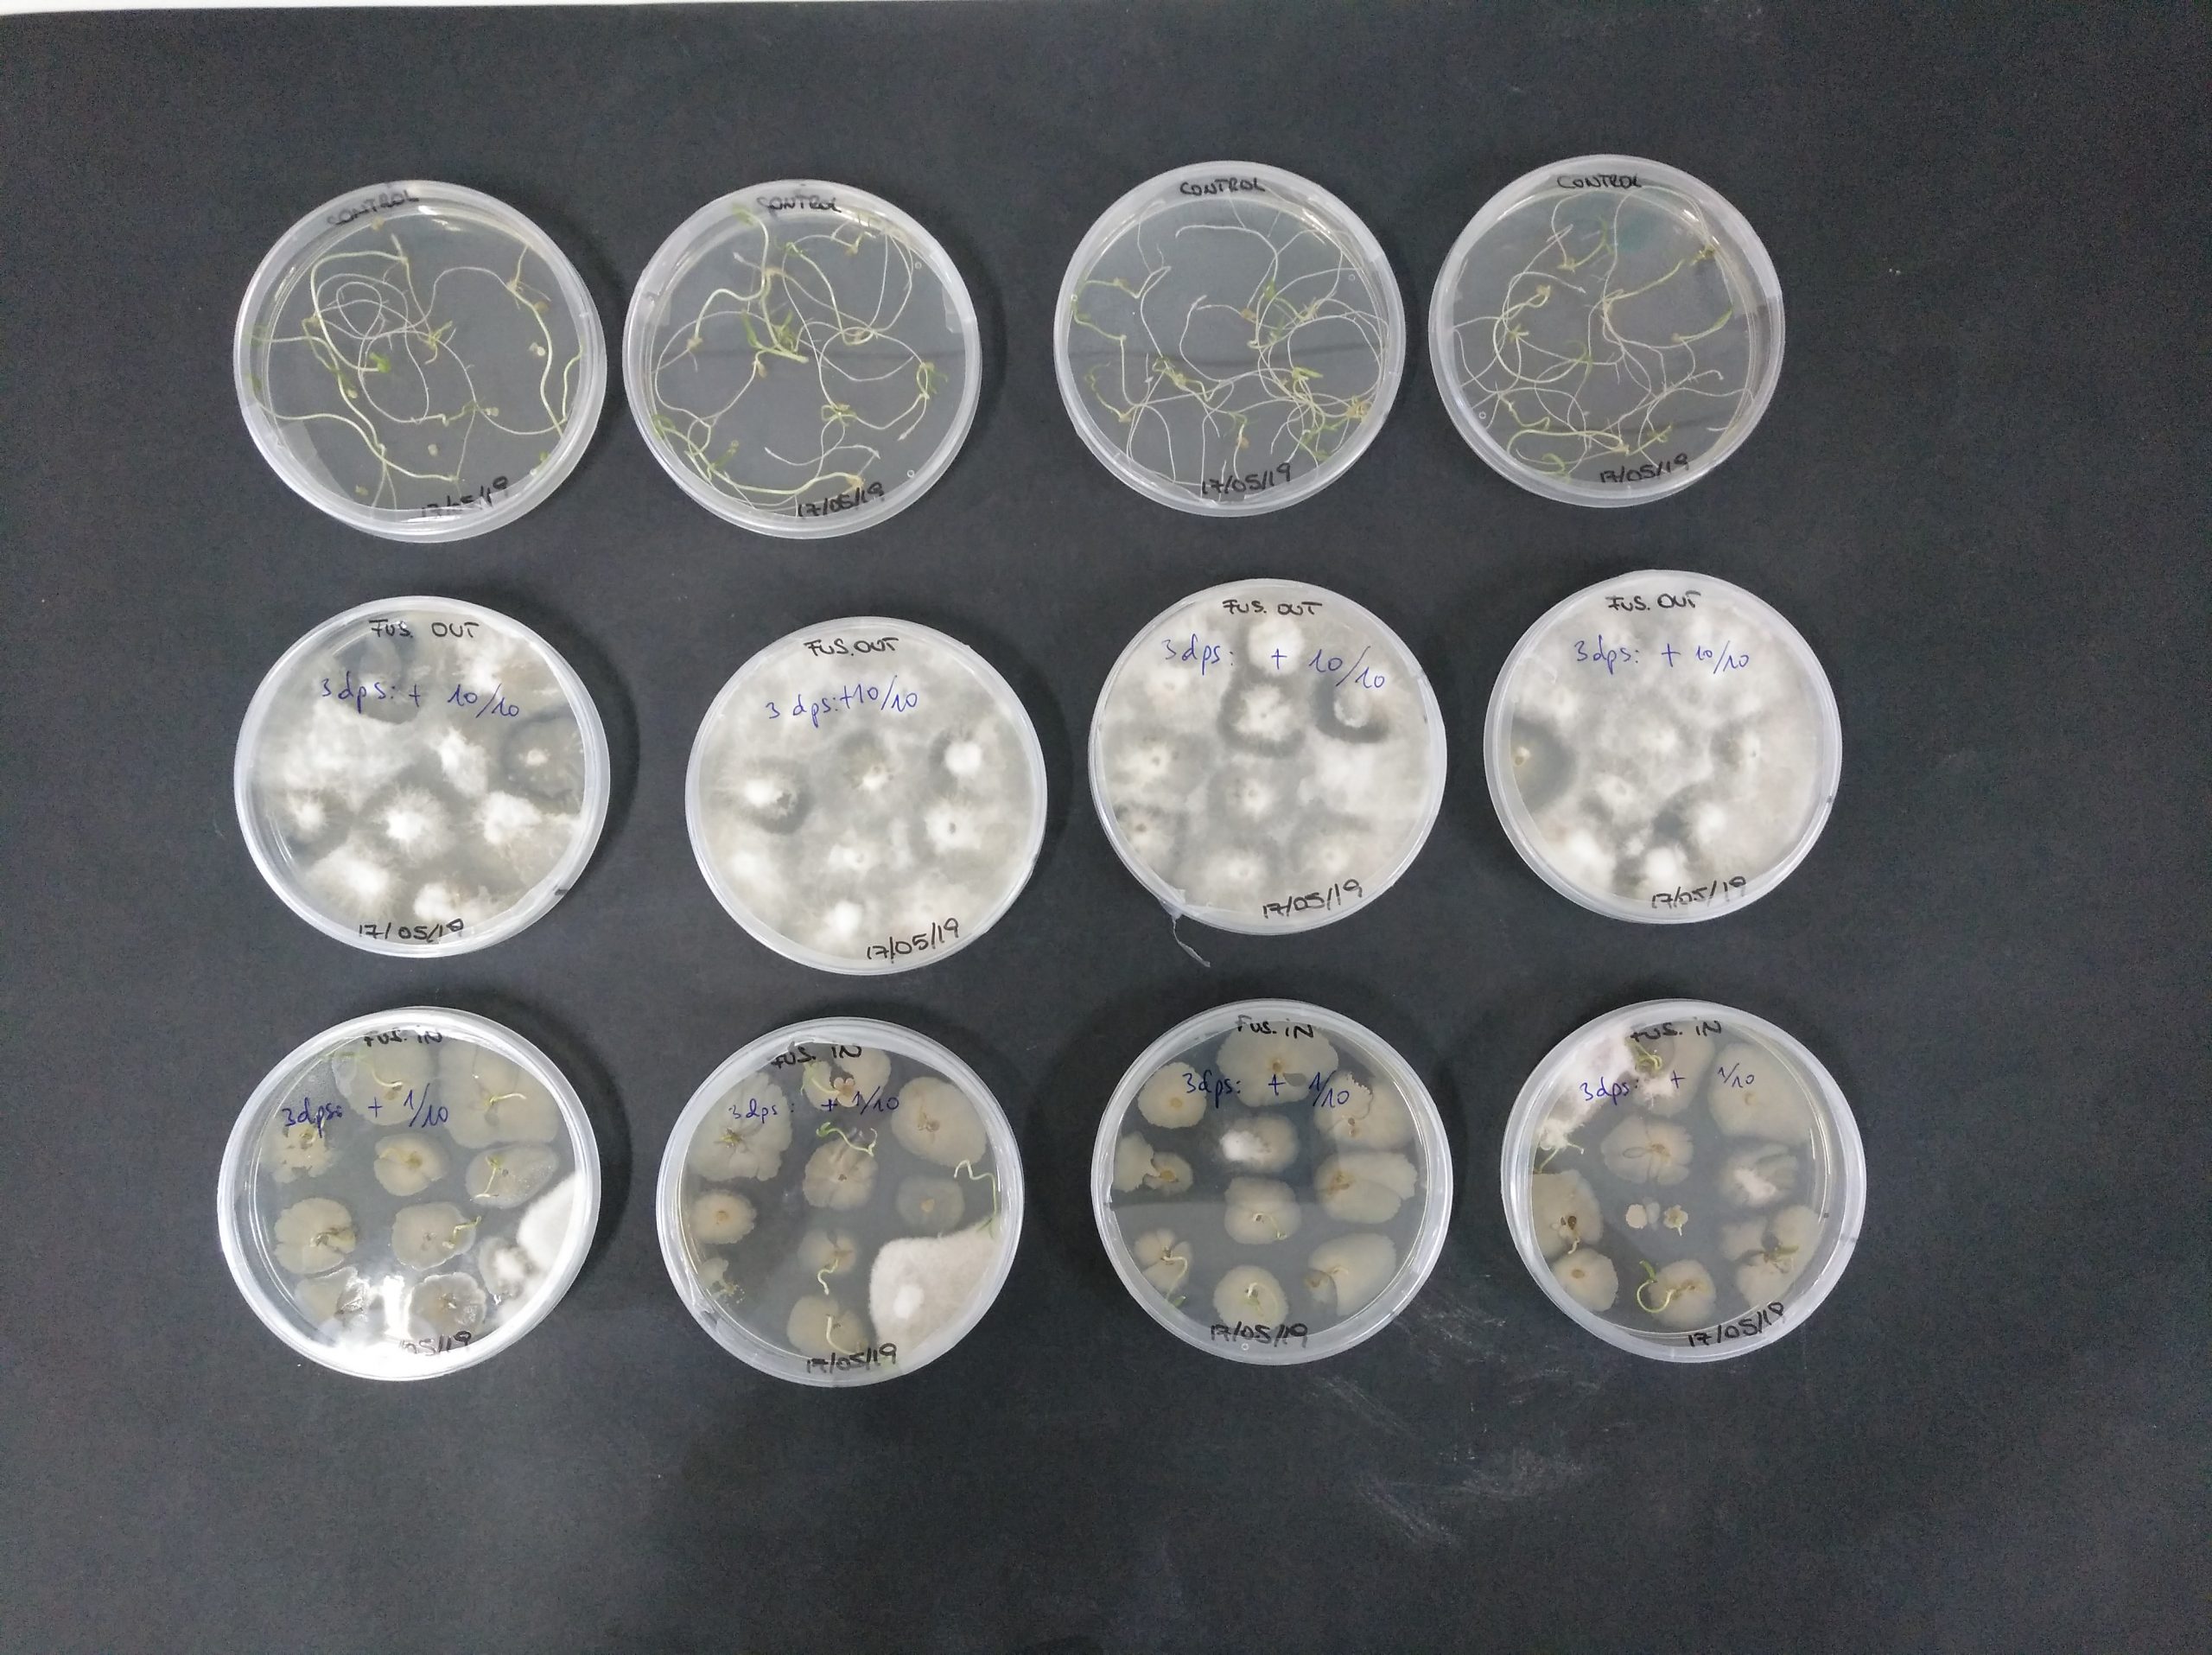

Descripción del proyecto
Objetivo del proyecto: Evaluar el potencial del sistema YTAG Pro+, tecnología patentada por la compañia norteamericana Yofumo Technologies, Inc., para la desinfección de semillas hortícolas sin la utilización de agentes químicos.
Más información sobre el proyecto en breve.
Proyecto desarrollado en colaboración con